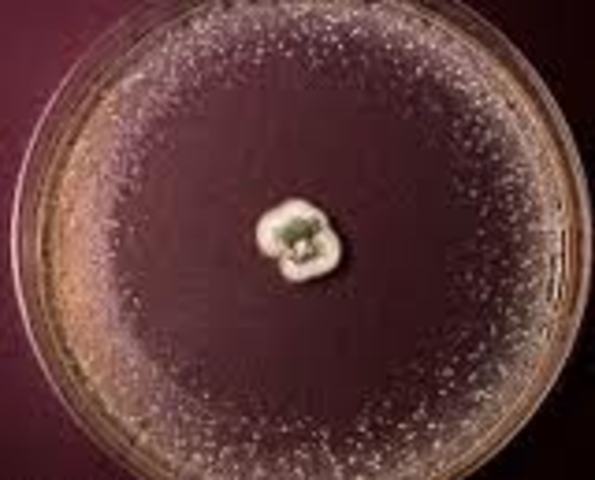
How does penicillin work?

-
-
-
Penicillin was a actually a mistake , because when Fleming and Forey came back from a holiday they found the mould on the plate and the mould was killing the bacteria.The penicillin was made before world war two and was the first wonder drug created.
-
Penicillin is an antibiotic that destroys Bacteria by destroying the cell wall of the microorganism.
Plan projects on a visual timeline
Map milestones, phases, deadlines, and key events in one place so the sequence is easier to see and share. Timetoast is a timeline maker for work, school, research, and stories.